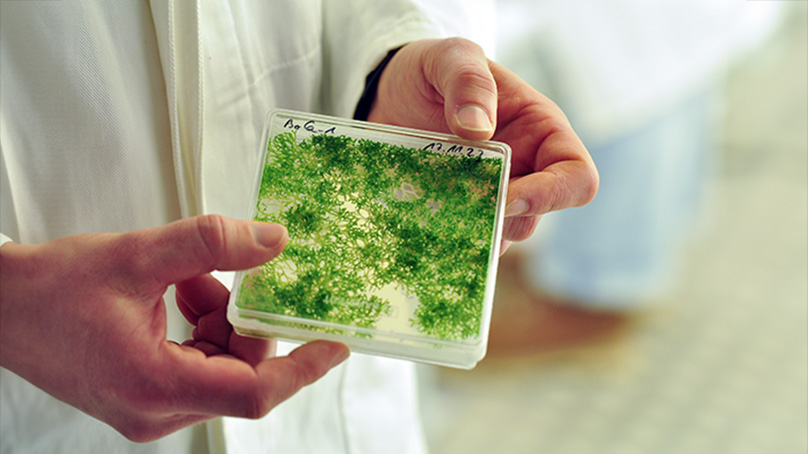
Was wir von Moosen über Klimaresilienz lernen können, erforscht das MAdLand Projekt <a href="/watertoland/">MadLand</a> . Die #UOS ist mit Teilprojekt beteiligt.

go.uos.de/3Cp5T

#Klima #Umweltschutz #Biologie #science #Klimawandel #research #Umwelt

Uni Osnabrück
@uniosnabrueck
Dieser Kanal wird nicht mehr bespielt. Wir bedanken uns für Ihr Interesse!
ID: 143241962
http://www.uni-osnabrueck.de 13-05-2010 00:01:32
5,5K Tweet
3,3K Takipçi
176 Takip Edilen














Vom 12. bis 18. November werden zur AGRITECHNICA wieder knapp eine halbe Million Fachbesucherinnen und -besucher in Hannover erwartet. Das Zukunftslabor Agrar stellt auf dem Stand des Agrotech Valley Forum e.V. einen Prototyp zur präzisen Aussaat vor. Mehr dazu: vt.uos.de/7ah35




Es ist eine herausragende Anerkennung für die Osnabrücker Migrationsforschung: Die DFG public | @[email protected] hat den Antrag auf Einrichtung des Sonderforschungsbereichs „Produktion von Migration“ an der #UOS zur Förderung ausgewählt: go.uos.de/RFj0G

MOOSland Verbundprojekt erforscht nachhaltige Landwirtschaft auf Moorflächen, #UOS ist mit Teilprojekt dabei. go.uos.de/syLo9 @univechta Uni Greifswald GreifswaldMireCentre #Klimaschutz #Agrar #Nachhaltigkeit #Umwelt #science #research